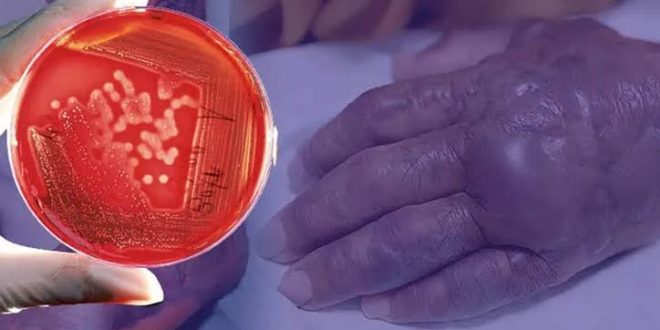
İnsan eti yiyen bakteri ABD'de yayılıyor!

ABD’nin Florida eyaletinde Ian kasırgasının ardından et yiyen bakteri vakaları artışa geçti.
Yetkililer, Florida‘nın Lee County bölgesinde et yiyen bakteri nedeniyle 29 vaka kaydedildiğini ve dört kişinin hayatını kaybettiğini açıkladı.
Sağlık yetkililerinin yaptığı açıklamada, Ian kasırgasının beraberinde getirdiği şiddetli yağışın neden olduğu sellerin bu bakterinin yayılmasına neden olduğu belirtildi.
BBC’nin haberine göre açıklamada, ciltte açık yaralar ya da kesikleri olan kişilerin, deniz suyuna doğrudan temas yoluyla bu bakteriye maruz kalabileceği uyarısı yapıldı.
Ian Kasırgası’nın neden olduğu gibi kıyı sularındaki kanalizasyon sızıntılarının bakteri seviyelerini artırabileceği aktarıldı.
Eyalet verilerine göre, bu yıl, bakteri kaynaklı toplam 11 ölüm ve 65 vaka kaydedildi.
Yetkililer, bu vakaların yarısının Ian Kasırgası sonrasında görüldüğünü tahmin ediyor.
Bilimsel adı ‘Nekrotizan Fasiit’ olan et yiyen bakteri, kesik ve çatlaklardan vücuda girerek kasların erimesine yol açıyor. Bakterinin kemiğe ulaşması halindeyse ölüm riski bulunuyor.
 Mira Haber – Ortadoğu Bağımsız Muhabir Ajansı Tarafsız değiliz. Ancak Mirahaber'de sadece gerçekleri okursunuz.
Mira Haber – Ortadoğu Bağımsız Muhabir Ajansı Tarafsız değiliz. Ancak Mirahaber'de sadece gerçekleri okursunuz.